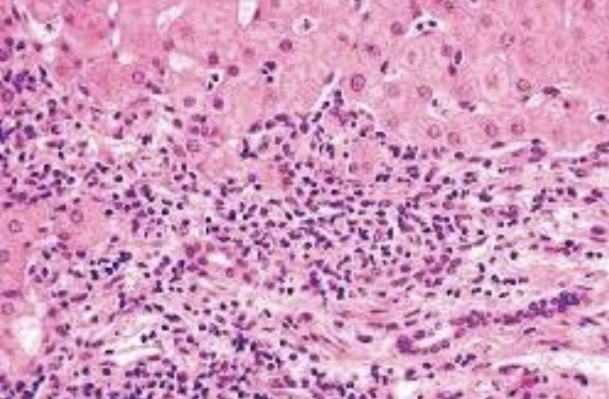
term image
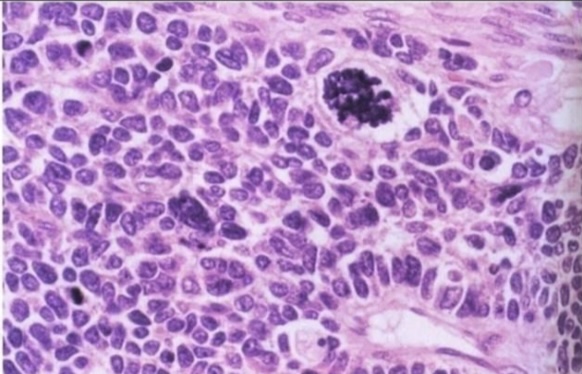
term image
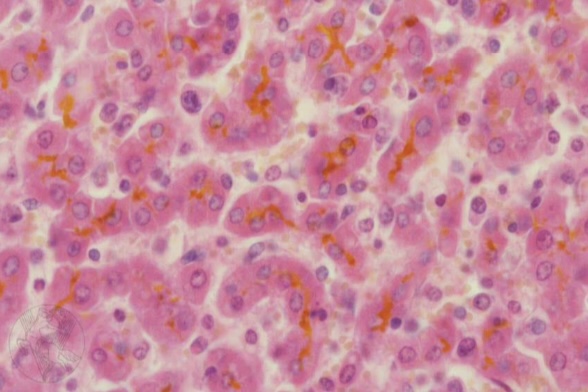
term image

PATHO101-B | Pathology General Histopath Slides (Exercise #3 & #4)
1/75
Earn XP
Description and Tags
slides from exercise 3 and 4 to study for midterm exams. please let me know if there are any corrections with pictures or labelings. best of luck! ◡̈
Name | Mastery | Learn | Test | Matching | Spaced | Call with Kai |
|---|
No analytics yet
Send a link to your students to track their progress
76 Terms

Intracellular and extracellular fluid

Ballooning degeneration

Nucleus and cytoplasm

Hydrophic degeneration

Degeneration

Hyaline degeneration

Necrosis

fibrinoid degeneration

Pyknosis

Mucoid degeneration

Cell swelling

Fatty degeneration
Fatty degeneration

Karyolysis

Colloidal degeneration

Complete absence of nucleus

Wallerian degeneration

Acidophilia

Cytoplasmolysis

Karyorrhexis

Loss of cell outline

Loss of differential staining

Caseation necrosis
Apoptosis in necrosis

Endocytosis

Hypoplasia

Dysplasia

Depot fat

Fatty infiltration

Congenital porphyria

Anthracosis

Steatosis

Fat necrosis

Complete absence of cytoplasm

Wet gangrene

Coagulative necrosis

Dry gangrene

Infarct

Liquefactive necrosis

Zenker’s necrosis

Autophagy

Apoptosis in normal tissues

Atrophy

Exocytosis

Hypertrophy

Hyperplasia

Heterophagy

Metaplasia

Hyaline degeneration

Dysplasia

Amyloid infiltration
Anaplasia

Cell swelling

Hydrophic degeneration

Gout

Glycogen infiltration

Albinism

Protoplasmic fat

Lipofuscin

Fatty degeneration

Ceroid
Bilirubin

Melanosis

Hemosiderin

Asbestosis

Icterus

Chalicosis

Pneumoconiosis

Hyalinization

Hyaline cast

Silicosis

Hyaline droplets

Corpora amylacea

Cholesterol clefts

Fibrinoid

Sphingomyelin

Fibrinoid